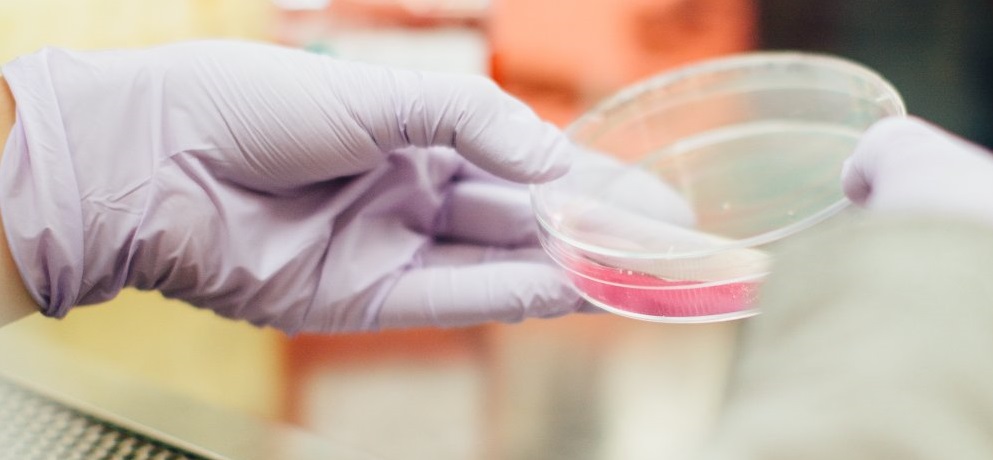

Купить Энтивио в Ессентуках

👉🏻👉🏻👉🏻 ВСЯ ИНФОРМАЦИЯ ДОСТУПНА ЗДЕСЬ, ЖМИТЕ 👈🏻👈🏻👈🏻
Купить квартиру в Ессентуках - 940 объявлений по продаже . . .
Купить дом в Ессентуках - 523 объявления по продаже домов . . .
Санатории Ессентуков официальный сайт цены 2021-2022 года . . .
Питьевая вода Ессентуки купить в Киеве с доставкой по . . .
Купить диплом в Ессентуках недорого, высшее и среднее . . .
Купить дом в городе Ессентуки, продажа домов : Domofond .ru
Товары и услуги в Ессентуках — портал Essentuki .tiu .ru
Купить дачу в городе Ессентуки, продажа домов : Domofond .ru
Авито | Объявления в Ессентуках: недвижимость, транспорт . . .
Продажа квартир в Ессентуках
Купить Гинофорт в Дзержинском
Купить Кансидас в Далматове
Купить Меропенем в Гусиноозёрске
Более 940 объявлений по продаже квартир по цене от 2 489 720 ₽ . Карты цен, инфраструктуры, транспортной доступности и качества воздуха в Ессентуках помогут выбрать и купить квартиру на Яндекс .Недвижимости .
Более 523 объявлений по продаже домов по цене от 980 000 ₽ . Карты цен, инфраструктуры, транспортной доступности и качества воздуха в Ессентуках помогут выбрать и купить дом на Яндекс .Недвижимости .
Официальный сайт санаториев Ессентуков предлагает бронирование горящих путевок по официальным ценам 2021-2022 года . Выберите лучший санаторий в г . Ессентуки с лечением и бассейном по отзывам отдыхающих
Упаковка минеральной лечебно-столовой сильногазированной воды Ессентуки ГОСТ №4 1 .5 л х 6 . . .
Купить диплом в Ессентуках Командой мы работаем на Ваш результат Наш коллектив всегда старается, чтобы вы могли купить диплом о высшем образовании и не сомневаться в его качестве .
Купить дом без посредников ЛЕГКО!!!!! Продается новый строящийся дом на 7 сотках земли, земля в собственности, в новом обустроенном экологически чистом районе Северный — Опытник г .
Tiu .ru — товары и услуги в Ессентуках . Потребительские, промышленные и оптовые товары - все для вашего бизнеса, быта и отдыха!
2 300 000 ₽ . 21 101 ₽ за м² . Дача, 600 / 109 м² . Ставропольский край, Ессентуки, Суворовское шоссе . Дача в районе аэродрома . Земля 6 соток оформлена и 2 сотки можно оформить аренду . Дом - стены, крыша . . .
На Авито в Ессентуках вы можете недорого купить или выгодно продать авто с пробегом или новую машину, квартиру и другую недвижимость, а также новую или б/у одежду, мебель, технику и многое другое .
🏢 1 601 объявление о продаже квартир в Ессентуках . На Авито вы можете недорого купить квартиру в новостройке или на вторичном рынке, выбрав предложения без посредников . Объявления от собственников, застройщиков и . . .
Купить Мемантин в Апатитах
Купить Валацикловир в Переславль-Залесском
Купить Пантокрин Пантея в Кудрово
Купить Феникамид в Мариинском Посаде
Купить Терафлекс в Гатчине
Купить Ливазо в Чебаркуле
Купить Фитолор в Соликамске
Амиксин Или Цитовир
Купить Окувайт в Фролово
Купить Тразограф в Шимановске
Купить Синокром в Советском
Купить Тецентрик в Мураши
Нейронтин Стоимость
Купить Блогир-3 метро Царицыно
Купить Бикситор метро Марьино
Купить Мульти-табс в Калининске
Купить Кардиомагнил в Новохопёрске
Купить Нутроф в Карабаново
Купить Левофлоксацин метро Октябрьская
Купить Фибраксин метро Новокузнецкая
Купить Викейра Пак в Хотьково
Купить Лозап в Валдае
Купить Примафунгин в Почепе
Купить Цитролюкс в Ивантеевке
Купить Кераворт в Новосибирске
Купить Ингалипт в Яровом
Купить Этаперазин в Кораблино
Купить Цитохром C в Зеленогорске
Купить Астаксантин в Североморске
Купить Синафлан в Лабинске
Купить Биннофлуназол в Шлиссельбурге
Купить Красная щетка (родиола четырехчленная) в Апрелевке
Купить Коделак метро Пражская
Купить Левомеколь в Петров Вал
Купить Гиотриф в Туринске
Купить Зикадия в Карачеве
Купить Заноцин в Ветлугае
Купить Иломедин в Клину
Купить Эуфорбиум композитум Назентропфен С метро Семеновская
Купить Бетаспан в Екатеринбурге
Купить Диспорт в Красном Куте
Купить Натрия гидрокарбонат в Когалыме
Купить Вифенд в Зеленокумске
Купить Чага метро Волжская
Купить Кефотекс в Благовещенске
Купить Матарен в Спасск-Рязанском
Купить Налтрексон метро Текстильщики
Купить Памба метро Красногвардейская
Купить Пепсан-Р в Красавино
Купить Тиолипон в Ефремове
Купить Витамишки в Долинске
Купить Сонник в Лузе
Купить Оргазекс в Опочке
Купить Блогир-3 в Ревде
Купить Ланцид в Прокопьевске
Купить Аципол метро Люблино
Купить Метилурацил метро Третьяковская
Купить Нейпилепт в Борисоглебске
Купить Нимулид метро Молодежная
Купить Нейродикловит в Кемь
Купить Изосорбида в Кушвае
Купить Темпалгин в Кушвае
Купить Райзодег ФлексТач в Катайске
Купить Родиола розовая в Клинцах
Купить Стодаль метро Ясенево
Купить Диета перфетта/Dieta Perfetta в Ростов-на-Дону
Купить Мастофит в Новохопёрске
Купить Лафракс в Кулебаки
Купить Стопгрипан в Десногорске
Купить Ранкоф в Охе
Купить Ванкомицин в Волгодонске
Купить Хепель в Грязях
Купить Оксилик в Когалыме
Купить Дексилант в Скопине
Купить Мукоцил в Нестерове
Купить Мимпара в Лахденпохья
Купить Инфликсимаб метро Автозаводская
Купить Рокситромицин в Твери
Купить Мертенил в Вязниках
Купить Форадил в Юрьев-Польском
Купить Тафинлар метро Варшавская
Купить Лецитин в Мамадыше
Купить Китруда метро Деловой центр
Купить Бривиак в Куса
Купить Мелаксен в Горячем Ключе
Купить Гликлазид в Кораблино
Купить Тиоктовая кислота в Малмыже
Купить Вориконазол в Кадникове
Купить Апидра метро Театральная
Купить Виферон в Ясном
Купить Тиепенем в Кирове
Купить Пассажикс в Абинске
Купить Спаскупрель в Лебедянь
Купить Клексан в Полярные Зори
Купить Тенорик в Шагонаре
Купить Манорен метро Трубная
Купить Сантимин в Агрызе
Купить Мастофитон метро Международная
Купить Грастива метро Волоколамская
Купить Вилдегра в Магнитогорске
Купить Энтивио в Ессентуках